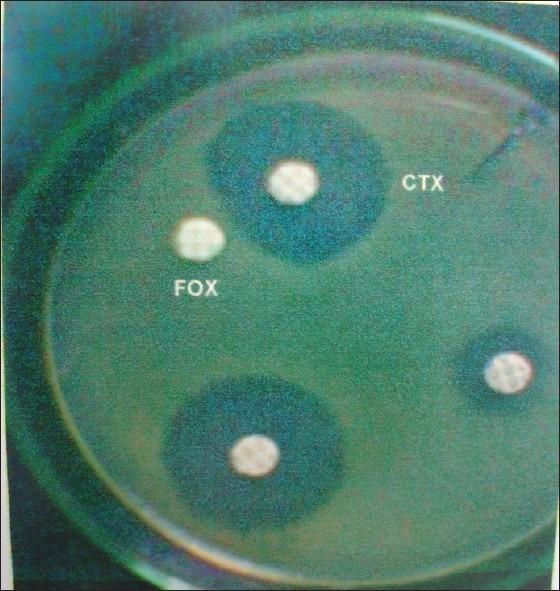
https://cdn.ncbi.nlm.nih.gov/pmc/blobs/307c/3506070/0f44438667bb/IJCCM-16-136-g001.jpg

烧伤患者中产AmpC酶铜绿假单胞菌临床分离株中不同β-内酰胺酶类别的负担:一项前瞻性研究。
Burden of different beta-lactamase classes among clinical isolates of AmpC-producing Pseudomonas aeruginosa in burn patients: A prospective study.
作者信息
Kumar V, Sen M R, Nigam C, Gahlot R, Kumari S
机构信息
Department of Microbiology, Institute of Medical Sciences, Banaras Hindu University, Varanasi, India.
出版信息
Indian J Crit Care Med. 2012 Jul;16(3):136-40. doi: 10.4103/0972-5229.102077.
BACKGROUND
Pseudomonas aeruginosa is one of the most common pathogens causing infections in burns, and shows increasing resistance to β-lactam antibiotics by producing different classes of beta-lactamases. It is also not unusual to find a single isolate that expresses multiple β-lactamase enzymes, further complicating the treatment options. Thus, in this study, we aimed to determine the coexistence of different beta-lactamase enzymes in clinical isolates of P. aeruginosa in the burn ward.
MATERIALS AND METHODS
A total of 101 clinical isolates of P. aeruginosa from the burn ward were identified and tested for the presence of different beta-lactamase enzymes (extended spectrum beta lactamase (ESBL), Amp C and metallo β-lactamases (MBL) from October 2006 to May 2009. In vitro susceptibility pattern of antipseudomonal antibiotics was done by the Kirby Bauer disc diffusion method.
RESULTS
A total of 33 (32.7%) isolates were confirmed to be positive for AmpC beta-lactamase. Co-production of AmpC along with ESBL and MBL was reported in 24.5% and 45.5% isolates, respectively. A total of 12 (11.9%) isolates were resistant to three or more antibiotic classes (multidrug resistance). Imipenem and piperacillin/tazobactum showed high sensitivity, with 86.1% and 82.2%, respectively.
CONCLUSION
This study reveals the high prevalence of multidrug- resistant P. aeruginosa producing beta-lactamase enzymes of different mechanisms in this region from burn patients. The emerging antimicrobial resistance in burn wound pathogens poses serious therapeutic challenge. Thus proper antibiotic policy and measures to restrict the indiscriminate use of cephalosporins and carbapenems should be taken to minimize the emergence of this multiple beta -lactamase producing pathogen.
背景
铜绿假单胞菌是烧伤感染最常见的病原体之一,通过产生不同类型的β-内酰胺酶,对β-内酰胺类抗生素的耐药性不断增加。发现单个分离株表达多种β-内酰胺酶的情况也并不罕见,这进一步使治疗选择复杂化。因此,在本研究中,我们旨在确定烧伤病房铜绿假单胞菌临床分离株中不同β-内酰胺酶的共存情况。
材料与方法
2006年10月至2009年5月,共鉴定了101株来自烧伤病房的铜绿假单胞菌临床分离株,并检测了不同β-内酰胺酶(超广谱β-内酰胺酶(ESBL)、AmpC和金属β-内酰胺酶(MBL))的存在情况。采用 Kirby Bauer 纸片扩散法检测抗假单胞菌抗生素的体外药敏模式。
结果
共有33株(32.7%)分离株被确认为AmpCβ-内酰胺酶阳性。分别有24.5%和45.5%的分离株报告同时产生AmpC与ESBL和MBL。共有12株(11.9%)分离株对三种或更多类抗生素耐药(多重耐药)。亚胺培南和哌拉西林/他唑巴坦显示出高敏感性,分别为86.1%和82.2%。
结论
本研究揭示了该地区烧伤患者中产生不同机制β-内酰胺酶的多重耐药铜绿假单胞菌的高流行率。烧伤创面病原体中不断出现的抗菌药物耐药性带来了严重的治疗挑战。因此,应采取适当的抗生素政策和措施,限制头孢菌素和碳青霉烯类药物的滥用,以尽量减少这种产生多种β-内酰胺酶病原体的出现。